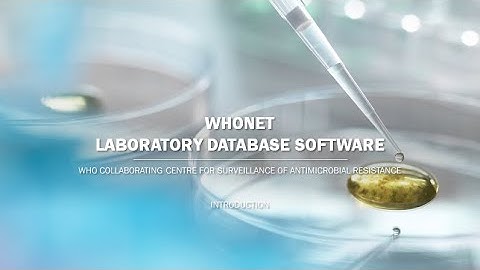
Download, Installation, and User Documentation

⬇ DOWNLOAD NOW
Kalau muncul iklan pop-up, tutup lalu klik tombol kembali
Download lagu WHONET 5 6 BacLink how to installed in windows systems secara gratis hanya untuk keperluan promosi. Dukung artis favorit kamu dengan membeli musik original di iTunes atau platform resmi lainnya.
 How to create Whonet Baclink Configuration
How to create Whonet Baclink Configuration
 Whonet Baclink Configuration for Different Test Methods
Whonet Baclink Configuration for Different Test Methods
 WHONET Installation, Configuration, and Data Entry
WHONET Installation, Configuration, and Data Entry
 BacLink Getting Started
BacLink Getting Started
Download, Installation, and User Documentation
Download, Installation, and User Documentation
 Whonet Baclink Process
Whonet Baclink Process
 WHONET BacLink Configuracion
WHONET BacLink Configuracion
 baclinkconfig
baclinkconfig